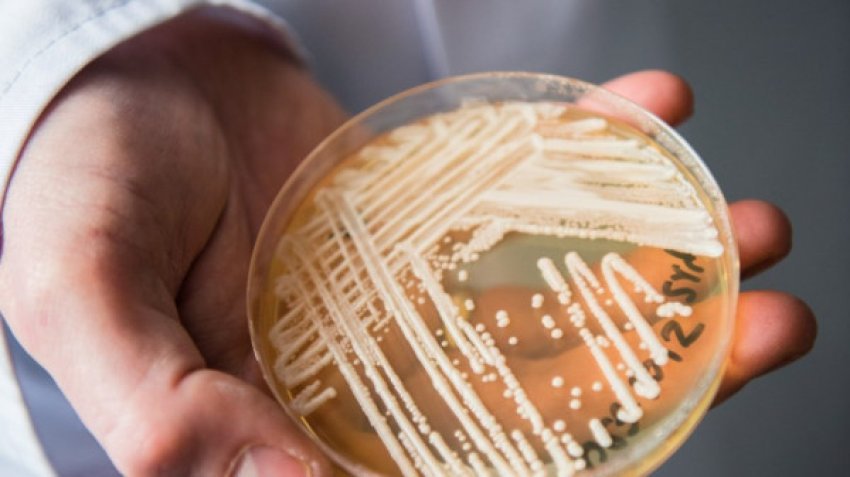
Një kërpudhë vrasëse alarmon spitalet evropiane 3 nje kerpudhe vrasese alarmon spitalet evropiane 68c4941c37853

Me lot në sy, i shkatërruar nga humbja e dy vajzave, që u shuan në lule të rinisë në një aksident automobilistik, Riza Dhimaku dha një mesazh të fortë për emisionin “Për shqiptarët”.
Jeta e Elvisës dhe Rozinës u ndërpre pabesisht pasi një automjet i preu rrugën. Në videomesazhin e tij, Rizai apelon për kujdes në drejtimin e mjetit, për të parandaluar tragjedi se kjo e familjes së tij.
“Të gjithë jemi me makina, të gjithë jemi shoferë. Pas atij aksidenti, kanë ndodhur aksidente të tjera në zonën tonë. Ju lutem ikni me mend në kokë, nuk ju ka borxh askush. Çdo gjë vjen nga shpejtësia dhe alkooli. Nuk ka gjë që mund ta falë, e gjykon Zoti. Unë mund ta fal, por nuk fal zemra, nuk fal shpirti… Sot më ndodhi mua, nesër mund t’i ndodhë një tjetri. Mos dëgjofshim më, mos ndodhshim më ngjarje të tilla”, theksoi Riza Dhimaku.
Top Channel
Burimi: top-channel.tv